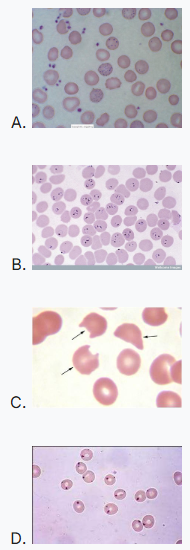
Most Missed IM - Lead Poisoning

Most Missed Question in Family Medicine Prep – Pituitary Hyperplasia
Severe primary hypothyroidism can cause TRH-driven pituitary hyperplasia that mimics a sellar mass. Learn the lab patterns boards test.
Lead toxicity boards review: classic vignette and the peripheral smear finding—coarse basophilic stippling—plus distractor breakdown and practice MCQs.
Lead toxicity is a classic boards presentation where the peripheral smear clue is coarse basophilic stippling.
A 23-year-old healthy man who works in a plant that manufactures pigments is brought to you by his wife. The patient is normally outgoing and expansive. For the last year his personality has changed and he has developed anxiety, cognitive decline, and hostility.
His physical examination reveals a blood pressure of 170/105 mm Hg. There is dark discoloration in the spaces between his teeth and gum in all of his lower incisors. There is evidence of sensory neuropathy on neurologic examination.
Laboratory evaluation shows anemia. His lactate dehydrogenase level is elevated and his haptoglobin level is low. You suspect lead poisoning.
What finding in the peripheral smear will be most likely found?
Basophilic stippling is the exam-reliable smear association for lead toxicity (coarse blue granules in RBCs representing aggregated ribosomal RNA). This vignette is loaded with occupational exposure (pigment manufacturing), neuropsychiatric change, HTN, neuropathy, hemolysis markers (↑LDH, ↓haptoglobin), anemia, and a gingival “lead line,” all of which support lead poisoning. CDC/ATSDR toxicology resources describe hematologic effects (anemia/hemolysis and disrupted heme synthesis); basophilic stippling remains a classic supportive smear clue used in test settings (confirmation is by blood lead level).
| Option | What It Tests / Implies | Why It’s Wrong Here |
|---|---|---|
| Image A | Basophilic stippling (lead, some hemoglobinopathies/thalassemias) | Correct for lead toxicity supportive smear finding. |
| Image B | Intraerythrocytic parasites (malaria) | No travel/fever/cyclic symptoms; occupational toxin story instead. |
| Image C | Bite cells (degmacytes) from splenic removal of Heinz body material | Points to oxidative hemolysis (e.g., G6PD), which doesn’t fit pigment/lead exposure + gingival lead line. |
| Image D | Heinz bodies (denatured Hb; typically needs supravital stain) | Suggests oxidative injury (G6PD, unstable Hb); not the highest-yield smear clue for lead. |
In a patient with occupational exposure + neuro/psychiatric symptoms + anemia, the smear clue you reach for is coarse basophilic stippling.
This item tests whether you can prioritize the *exposure history and toxidrome* over a generic “hemolysis” lab pattern. Boards commonly pair lead exposure with neurocognitive changes, neuropathy, HTN, and gingival discoloration—then ask for the one hematology image association that should become reflexive: basophilic stippling.
A 41-year-old battery plant worker has abdominal pain, constipation, wrist drop, and microcytic anemia. Which peripheral smear finding is most supportive?
A — Review: suggests hereditary spherocytosis/AIHA.
B — Correct response!: lead toxicity classically shows coarse basophilic stippling (impaired heme synthesis/rRNA degradation).
C — Review: suggests MAHA/TTP/DIC/mechanical hemolysis.
D — Review: hyposplenism/asplenia.
E — Review: megaloblastic anemia (B12/folate).
A man develops jaundice and dark urine after taking TMP-SMX; smear shows “blister/bite” cells. What is the best interpretation?
A — Review: lead suggests basophilic stippling, not bite cells.
B — Correct response!: bite cells reflect splenic removal of Heinz body material in oxidative stress (G6PD).
C — Review: would show intraerythrocytic parasites.
D — Review: macro-ovalocytes/hypersegmented neutrophils.
E — Review: spherocytes + positive DAT.
A patient with suspected chronic occupational lead exposure has anemia and neuropathy. What is the confirmatory diagnostic test?
A — Review: evaluates iron deficiency; not confirmatory for lead.
B — Correct response!: blood lead level is the diagnostic confirmation (CDC/ATSDR).
C — Review: supports hemolysis but is nonspecific.
D — Review: helps classify anemia but not etiologic confirmation.
E — Review: evaluates immune hemolysis.
A febrile traveler with cyclic chills has anemia; smear shows ring forms within RBCs. Best diagnosis?
A — Review: basophilic stippling, not parasites.
B — Correct response!: intraerythrocytic parasites/ring forms are classic.
C — Review: would show bite cells/Heinz bodies after oxidant stress.
D — Review: target cells/microcytosis; no parasites.
E — Review: sickled forms, Howell–Jolly bodies if functional asplenia.
Which pairing is most accurate?
A — Review: Howell–Jolly = asplenia/hyposplenism.
B — Review: warm AIHA = spherocytes + DAT+.
C — Correct response!: classic supportive smear clue for lead toxicity.
D — Review: hypersegmented neutrophils = B12/folate deficiency.
E — Review: malaria = intraerythrocytic parasites.
How would your differential and first confirmatory test change if the same patient had episodic hemolysis after fava beans and the smear showed bite cells rather than basophilic stippling?
Q1: Is basophilic stippling specific for lead poisoning?
A: No—boards treat it as a high-yield association (also seen in some thalassemias), but the ABIM-style expectation is to connect it to lead when the exposure/neuro/gingival clues are present.
Q2: What confirms suspected lead poisoning?
A: A venous whole blood lead level; smear findings are supportive but not diagnostic (CDC/ATSDR 2020).
Q3: Why does lead cause anemia?
A: Lead disrupts heme synthesis pathways and can contribute to hemolysis; exam questions often bundle this with neuro/renal/HTN findings to force recognition.
Q4: How do I avoid confusing lead with G6PD deficiency on smear questions?
A: Lead → basophilic stippling; G6PD/oxidative hemolysis → Heinz bodies (supravital stain) and bite cells.
This question appears in Med-Challenger Internal Medicine Review with CME
Try for free and save. Ace your exams and meet your CME/MOC requirements for just $35 a month!
No matter your program, no matter the size, Med-Challenger for Groups and Institutions can better prepare your program or group, fulfill industry requirements, and increase test scores.
For personal medical education that includes board's prep, MOC, and CME requirements, Med-Challenger has you covered in Family Medicine, Emergency Medicine, Internal Medicine, Pediatrics, Pediatric Emergency Medicine, OBGYN, Physician Assistants, and Nurse Practitioners.Severe primary hypothyroidism can cause TRH-driven pituitary hyperplasia that mimics a sellar mass. Learn the lab patterns boards test.
In children under 2 with scalp bite punctures/avulsion, CT head is often the next step to rule out skull fracture or intracranial penetration.
Most missed question in Emergency Medicine. Three rapidly life-threatening gynecologic emergencies that should be considered in every female of...
Stay informed of new medical education content, certification requirements and deadlines, case-based CME quizzes, and special offers.